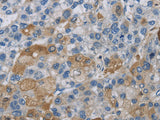
DNAJB4 Polyclonal Antibody Store at -20°C

DNAJB4 Polyclonal Antibody Store at -20°C
SKU: E-AB-11163-200
DNAJB4 Polyclonal Antibody Store at -20°C
| SKU # | E-AB-11163 |
| Reactivity | Human, Mouse |
| Host | Rabbit |
| Applications | WB, IHC |
Product Details
| Isotype | IgG |
| Host | Rabbit |
| Reactivity | Human, Mouse |
| Applications | WB, IHC |
| Clonality | Polyclonal |
| Immunogen | Recombinant protein of human DNAJB4 |
| Abbre | DNAJB4 |
| Synonyms | DNAJW, DjB4, HLJ1 |
| Swissprot | |
| Calculated MW | 38 kDa |
| Cellular Localization | Cytosol, Extracellular region or secreted, extracellular exosome, Plasma Membrane. |
| Concentration | 0.9 mg/mL |
| Buffer | Phosphate buffered solution, pH 7.4, containing 0.05% stabilizer and 50% glycerol. |
| Purification Method | Affinity purification |
| Conjugation | Unconjugated |
| Storage | Store at -20°C Valid for 12 months. Avoid freeze / thaw cycles. |
| Shipping | The product is shipped with ice pack,upon receipt,store it immediately at the temperature recommended. |
Related Reagents
| Applications | Recommended Dilution |
| WB | 1:500-1:2000 |
| IHC | 1:25-1:100 |
Background
DNAJB4 belongs to the evolutionarily conserved DNAJ/HSP40 protein family. For background information on the DNAJ family, see MIM 608375.